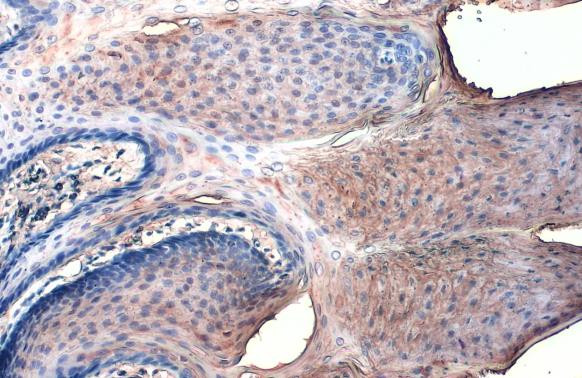
Collagen I Antibody in Immunohistochemistry (Paraffin) (IHC (P))

Search
Invitrogen
Collagen I Monoclonal Antibody (COL-1)
{{$productOrderCtrl.translations['antibody.pdp.commerceCard.promotion.promotions']}}
{{$productOrderCtrl.translations['antibody.pdp.commerceCard.promotion.viewpromo']}}
{{$productOrderCtrl.translations['antibody.pdp.commerceCard.promotion.promocode']}}: {{promo.promoCode}} {{promo.promoTitle}} {{promo.promoDescription}}. {{$productOrderCtrl.translations['antibody.pdp.commerceCard.promotion.learnmore']}}
图: 1 / 9
Collagen I Antibody (MA1-26771) in IHC (P)









产品信息
MA1-26771
种属反应
已发表种属
宿主/亚型
分类
类型
克隆号
抗原
偶联物
形式
浓度
规格
保存液
内含物
保存条件
运输条件
RRID
产品详细信息
The antibody is reactive with the native (helical) form of collagen type I in ELISA and dot blot. The product is not reactive when tested on thermally denatured molecules. In immunohistochemical staining of acetone-fixed and unfixed frozen sections, a strong staining of connective tissue fibers is seen. Using the dot blot and ELISA techniques, the antibody shows no cross-reactivity with collagen types, II, III, IV, V, VI, VII, IX, X and XI. The epitope recognized by the antibody is sensitive to routine formalin fixation and paraffin embedding.|Store product as a concentrated solution. Centrifuge briefly prior to opening the vial.
靶标信息
Collagen I is a Type I collagen with a triple helix structure comprised of two alpha-1 chains and one alpha-2 chain. Collagen I is a member of group I collagen (fibril-forming collagen) found in most connective tissues, and is abundant in bone, cornea, dermis and tendon. Mutations in the COL1A2 gene encoding the alpha-2 chain are associated with osteogenesis imperfecta types I-IV, Ehlers-Danlos syndrome type VIIB, recessive Ehlers-Danlos syndrome Classical type, idiopathic osteoporosis, and atypical Marfan syndrome. Symptoms associated with mutations in the COL1A2 gene which codes for the alpha-2 chain, however, tend to be less severe than mutations in the COL1A1 gene, reflecting the different role of alpha-2 chains in matrix integrity. Reciprocal translocations between chromosomes 17 and 22, where Collagen Type 1 genes and the gene for platelet derived growth factor beta are located, are associated with a particular type of skin tumor called dermatofibrosarcoma protuberans, resulting from unregulated expression of the growth factor. Two transcripts, resulting from the use of alternate polyadenylation signals, have been identified.
仅用于科研。不用于诊断过程。未经明确授权不得转售。
生物信息学
蛋白别名: alpha 1 (I) chain propeptide; alpha 1 type I collagen; alpha 2 type I procollagen; alpha 2(I) procollagen; alpha 2(I)-collagen; alpha-1 collagen type 1; alpha-1 collagen type I; alpha-1 type 1 collagen; Alpha-1 type I collagen; Alpha-2 type I collagen; alpha1 chain of type I collagen; alpha1(I) procollagen; alpha2 chain of type I collagen; COL1; COL1A1; COL1A1; matrix protein; collagen 1 alpha 2 chain; collagen 1 pro-alpha-2 chain; collagen alpha 1 chain type I; Collagen alpha-1(I) chain; collagen alpha-1(I) chain preproprotein; Collagen alpha-2(I) chain; collagen Col1-ColIII-1; collagen Col1-ColIII-2; collagen COL1A2; collagen I alpha-2 polypeptide; collagen I, alpha-2 polypeptide; collagen of skin, tendon and bone, alpha-1 chain; collagen of skin, tendon and bone, alpha-2 chain; collagen type I alpha 1; collagen, type 1, alpha 1; collagen, type I, alpha 1; collagen, type I, alpha 2; epididymis secretory sperm binding protein; osteogenesis imperfecta; pre-pro-alpha-2 type I collagen; prepro-alpha-1 collagen type I; pro-alpha-1 collagen type 1; procollagen type I, alpha 1; procollagen, type 1, alpha 1; procollagen, type I, alpha 1; procollagen, type I, alpha 2; Type I Collagen; type I proalpha 1; type I procollagen; type I procollagen alpha 1 chain; type I-alpha 1 collagen; unnamed protein product
基因别名: AA960264; AI325291; CAFYD; Col1a-1; Col1a-2; COL1A1; COL1A2; Cola-1; Cola-2; Cola1; Cola2; COLIA1; EDSARTH1; EDSARTH2; EDSC; EDSCV; Mov-13; Mov13; OI1; OI2; OI3; OI4; oim